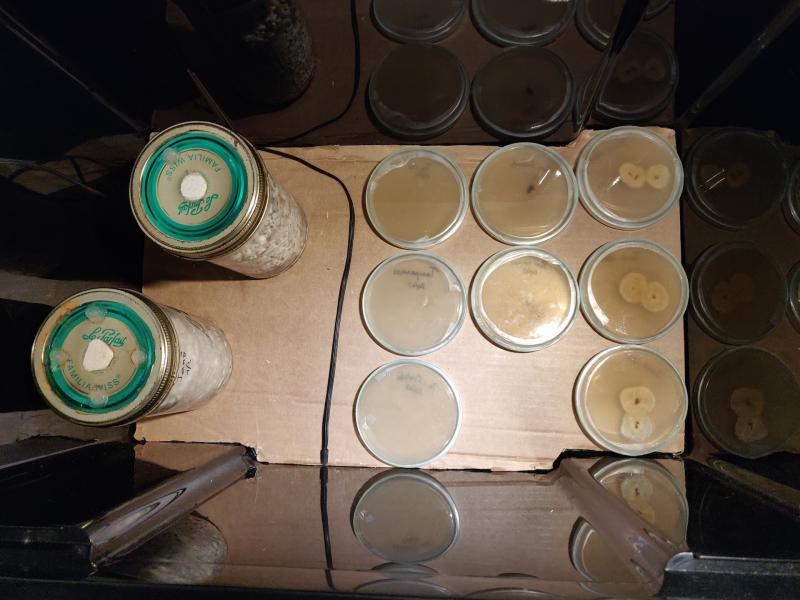
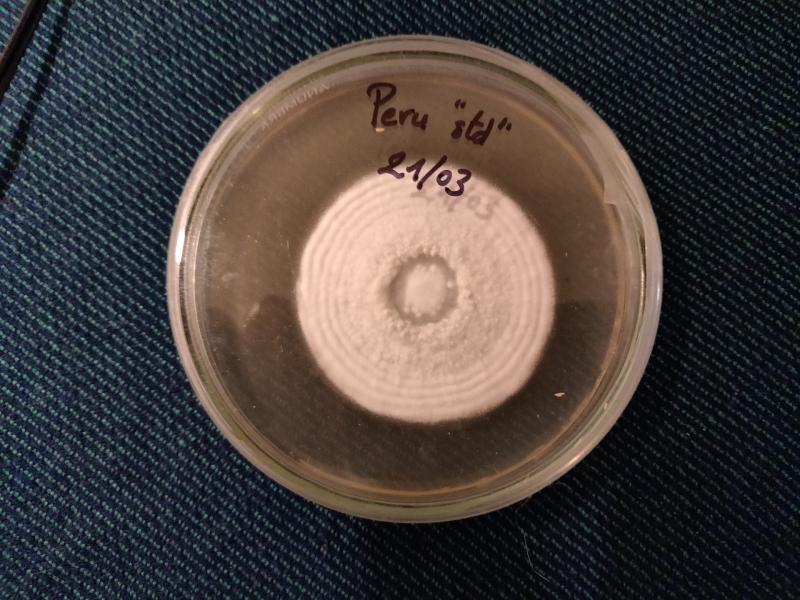

Dernière modification par Daane-El (01 mai 2020 à 14:21)
Hors ligne

Hors ligne


Dernière modification par Daane-El (01 mai 2020 à 14:32)
Hors ligne

), moins de bodyload (effet stoned), et empathogène/aphrodisiaque. Ça devrait être intéressant avec l'harmaline qui devrait peut-être permettre à la sérotonine de passer dans le cerveau...

Hors ligne

Ianômami
Je suppose que ces indiens en consomment ?
Tu sais dans quel cadre, quelles quantités ?
Hors ligne

Mister No a écrit
Merci du partage, ça donne envie de me remettre aux champottes et pas que les psychotropes.
Ianômami
Je suppose que ces indiens en consomment ?
Tu sais dans quel cadre, quelles quantités ?
Justement, je n'ai jamais eu vent de l'utilisation des champignons par les cultures indigènes en Amérique du Sud, ce que je trouve étrange, vu que le champignon n'a rien à envier à l'ayahuasca ou beaucoup d'autres plantes disponibles là bas. De plus, au Brésil d'où le Ianômami est originaire, il a un statut quasi légal, en tout cas on ne risque pas d'ennuis avec la police à le cultiver, le récolter dans la nature et bien évidemment le consommer.
https://en.wikipedia.org/wiki/Yanomami
Wiki raconte qu'ils utilisent le yopo et le ebene, du yopo avec du virola (bufotenine + 5-MeO-DMT ?), me ne font pas mention des champignons...
Dernière modification par SillyCone (24 mars 2019 à 23:04)
Hors ligne

Dernière modification par Mister No (28 mars 2019 à 21:23)
Hors ligne

Dernière modification par SillyCone (03 avril 2019 à 21:11)
Hors ligne






)
Dernière modification par SillyCone (04 avril 2019 à 11:00)
Hors ligne

Hors ligne

Dernière modification par SillyCone (06 avril 2019 à 07:52)
Hors ligne

Hors ligne

Cheppa a écrit
1360g... laisse moi t'appeller sensei ^^ et sinon ça représente combien une fois séché ?
Normalement le ratio est de 10, donc ça doit faire environ 136g secs !
Hors ligne

Mybrwelt a écrit
Cheppa a écrit
1360g... laisse moi t'appeller sensei ^^ et sinon ça représente combien une fois séché ?
Normalement le ratio est de 10, donc ça doit faire environ 136g secs !
En fait, le ratio quand c'est bien sec (au four ou au déshydrateur) est plutôt de 11 : 1360g frais >> 120g secs.
Hors ligne


Dernière modification par Maska (12 avril 2019 à 14:24)
Hors ligne


Dernière modification par SillyCone (12 avril 2019 à 16:59)
Hors ligne

SillyCone a écrit
mais la Peru dans les mêmes conditions ne produit pas la moitié
Le problème viens peut-etre de la, ils sont comme même capricieux même si ils ont des caractère similaire autant certaines conditions n'étais pas requise pour leurs réel progression en tout cas leurs formes arrondie et super strange ont dirait qu'il ont eue un manque quelque part pourtant la base du tronc est assez considérable, a voir tes prochains essaies !
Qu'est ce que tu entend par Multi-spore ? Différent spore dans une culture liquide ?
Hors ligne

Maska a écrit
SillyCone a écrit
mais la Peru dans les mêmes conditions ne produit pas la moitié
Le problème viens peut-etre de la, ils sont comme même capricieux même si ils ont des caractère similaire autant certaines conditions n'étais pas requise pour leurs réel progression en tout cas leurs formes arrondie et super strange ont dirait qu'il ont eue un manque quelque part pourtant la base du tronc est assez considérable, a voir tes prochains essaies !
Non, les conditions sont parfaites pour tous les cubensis (et la majorité des psilocybes/panaeolus tropicaux) : 23-24ºC et 90%HR.
C'est juste la caractéristique des péruviens et des Ianômamis. En tout cas c'est la caractéristique des phénotypes que j'ai eu sur ce coup.
Maska a écrit
Qu'est ce que tu entend par Multi-spore ? Différent spore dans une culture liquide ?
On parle de multispore par opposition aux clones, qu'on appelle des isolations.
Le multispore, c'est quand on part d'une empreinte de spores, dans laquelle il y a des milliers voir des millions de phénotypes différents. Quand tu fais germer des spores à partir d'une seringue dans une PFTek par exemple, tu te retrouves en fait avec des centaines d'individus qui sont en concurrence.
Un clone, ou une isolation, c'est isoler un seul individu et ne dupliquer que celui-là.
2 techniques pour ce faire (à ma connaissance). Soit faire germer une goutte de spores sur de l'agar (dans des boîtes de Petri) et sélectionner les brins de mycélium les plus vigoureux pour les isoler dans une autre boîte de Petri et ensuite les passer en grain et en culture liquide, soit faire fructifier le champignon à partir de spores, et cloner un beau champignon sur de l'agar, et passer directement de l'agar au grain et à la culture liquide. C'est ce que j'ai fait ici, je trouve ça plus simple que de faire des sélections sur agar.
Hors ligne

Dernière modification par SillyCone (19 avril 2019 à 21:26)
Hors ligne

VIsioman a écrit
Magnifique !
+1 c'est clair
à la relecture, je ne trouve pas les détails suivants qui m'intéresseraient bien pour tout bien comprendre:
- combien de gypse dans ton mélange coco/crottin? pour quelle fonction?
- pour le seigle, les 10h dans le café, c'est avant ou après cuisson du grain? ça marche sans? alors pourquoi en mettre?
- quand tu spawne le grain+mycélium dans ton mélange coco+crottin+gypse, quelle répartition? tu le fais à l'air ou devant le flux laminaire?
- tu laisses les bacs de coco+crottin+gypse+mycélium à l'air dans les incubateurs?
en tout cas merci pour le topic.... ça me vend du rêve! :)
et merci par avance pour les réponses
Hors ligne

Plotchiplocth a écrit
à la relecture, je ne trouve pas les détails suivants qui m'intéresseraient bien pour tout bien comprendre:
- combien de gypse dans ton mélange coco/crottin? pour quelle fonction?
Ben les ricains disent de mettre 5% de gypse (en volume). Au prix du gypse, ça me paraît énorme (ça en ferait le composant le plus cher de tout le processus), j'en mets peut-être 2-3% max ?
Le gypse apporte du calcium, stabilise le pH vers le haut (contre les bactéries qui aiment les milieux acides) car le crottin a tendance à être acide à cause des nitrates des urines du cheval et est un agent anti-coagulant en aspirant l'humidité.
Normalement, on devrait pouvoir utiliser des plaques de placo, c'est supposé être du gypse à quasi 100%. Du moins y en a un paquet qui clament qu'ils n'utilisent que ça et que ça marche très bien, faut juste avoir envie de casser du placo à la masse.
J'en ai trouvé en ligne à 35€ (fdp inclus en France) pour 10kg (ou 67€ pour 25kg), en tant que "sulfate de calcium dihydraté" ou "gypse agricole", ce qui reste raisonnable...
Plotchiplocth a écrit
- pour le seigle, les 10h dans le café, c'est avant ou après cuisson du grain? ça marche sans? alors pourquoi en mettre?
C'est pendant le trempage du grain, avant la cuisson.
Idéalement, changer l'eau pour la cuisson finale de 10 minutes afin de virer l'amidon, comme ça les grains colleront beaucoup moins et seront plus faciles à sécher juste après la cuisson.
Oui, ça marche sans, mais ça marche mieux avec :)
Le café apporte des nutriments qui boostent la croissance du mycélium dans le grain. Et là c'était un batch spécial pour le Tampanensis, apparemment les psilocybes à truffes aiment particulièrement le café...
C'est le genre de petites optimisations qui permettent d'atteindre des temps de colonisation record, genre 6 jours pour coloniser 1L de grains à partir de culture liquide...
Plotchiplocth a écrit
- quand tu spawne le grain+mycélium dans ton mélange coco+crottin+gypse, quelle répartition? tu le fais à l'air ou devant le flux laminaire?
coco+crottin à 50/50, puis je rajoute 5% en volume de gypse (CaSO4 - sulfate de calcium dihydraté). Donc par exemple, 10L de coco + 10L de crottin + 1L de gypse, mais en pratique je mets moins de gypse que ça et ça passe bien jusque là.
C'est la beauté de travailler en pasteurisé, c'est que je peux faire ça à l'air libre, avec les mains nues si je veux (je préfère néanmoins utiliser des gants et tout passer à l'alcool auparavant.)
Plotchiplocth a écrit
- tu laisses les bacs de coco+crottin+gypse+mycélium à l'air dans les incubateurs?
Non, ils ont un couvercle donc les trous sont recouverts de Micropore. Si pas de couvercle, recouvrir d'une feuille d'aluminium avec quelques trous percés à la fourchette pour permettre au mycélium de respirer. À ce stade, il se développe bien à l'air libre, protégé par les micro-organisme du crottin gardés en vie par la pasteurisation.
Je préfère les couvercles qui me permettent d'empiler les bacs dans les incubateurs et de checker de temps en temps pour vérifier l'évolution du mycélium et s'il y a contamination dans quel cas il me faut virer le myc pour éviter qu'il ne contamine les autres...
Plotchiplocth a écrit
en tout cas merci pour le topic.... ça me vend du rêve! :)
et merci par avance pour les réponses
Avec joie ! Moi je dirais plutôt que ça vend de la réalité
Hors ligne

Dernière modification par Plotchiplocth (24 avril 2019 à 17:40)
Hors ligne

Plotchiplocth a écrit
Je suis habitué à la création d automates de régulation air/solutions nutritives, aux manipulations stériles, et j ai déjà tout le matériel. Pourquoi pas tenter? A voir
En plus, la voie royale !
Tu vas te régaler avec la myco, c'est un être captivant à observer le mycélium, et puis tu vas pouvoir te faire plaisir à construire tes chambres de fructification en allant aussi high-tech que le coeur t'en dit
(ce qui permet de fruiter autre chose que l'éternel cubensis, comme le Ps.Mexicana, les panaeolus (cyanescens, tropicalis, cinctulus, ...) et autres champignons tropicaux avec un profil et une puissance souvent plus élevés)
Bien cool tout ça ! Welcome, bro
Dernière modification par SillyCone (24 avril 2019 à 20:59)
Hors ligne

SillyCone a écrit
Une fois qu'on a fait l'investissement de base (autoclave - 130€, pots - Le Parfait à 20€ les 12, incubateur - 3 bacs, thermostat et chauffage d'aquarium, le tout à 40€, et chambre de fructification - une serre à 40€, un humidificateur à 40€ et thermostat plus tapis chauffant à 40€), produire du cubensis ne coûte quasi que dalle : 25kg de seigle à 25€
Hors ligne

Hors ligne

SillyCone a écrit
Ben le truc c'est qu'il n'y a pas de raccourcis...
Je peux te donner quelques infos mais si tu n'y parviens pas par toi-même, tu ne sauras pas quoi en faire.
La mycologie est un apprentissage continu et en direct.
Ceci dit...
Mon autoclave est une Presto 23qt sur Amaz*n.
Les thermostats sont des STC-1000 à 7€ en Chine sur eb*y.
Tu trouveras les pots "Le Parfait" dans toutes les grandes surfaces et les "filter discs" sur e**y.
La serre se trouve aussi en grandes surfaces de bricolage section jardinage (logique.)
Pour le reste, mon matos, c'est 8 ans d'expérimentation pour trouver ce qui me plaît à moi, selon ma manière d'être du moment avec ce que j'ai trouvé autour de moi. (j'habitais pas la France quand j'ai commencé la myco)
C'est pas du tout garanti que ce soit ce qui te convient à toi...
Ouais, merci mais je prefere quand meme acheter une ecosphere toute prete de chez M..............com tres bon site MGK ils vendent tout le materiel necessaire comme des boitrs pour sechage, des lampes a Uv pour steriliser et remplacer l'autoclave ce que je trouve super! Vas y jeter un coup d'oeuil ça vaut le coups crois moi
Tchuss:peace:
Dernière modification par Daane-El (01 mai 2020 à 14:36)
Hors ligne

SillyCone a écrit
Bien cool tout ça ! Welcome, bro
j'ai mis le pied dedans 
merci pour l’intérêt communiqué à travers tes différents topics 
(et lu avec attention l'"aventure" monotub de Licky Narson, tu y réponds à de nombreuses questions)
je laisse ton sujet tranquille et continue à le suivre avec attention
j'ouvrirai peut-être un blog ou poserai mes questions "au vol" dans le forum dédié
j'ai plein de trucs à essayer...
l'objectif est de remplacer mes prises occasionnelles de RC peu sécurisables par quelque chose de plus naturel et accessible en autoproduction sans trop d'intrants
Dernière modification par Plotchiplocth (06 mai 2019 à 15:12)
Hors ligne

Hors ligne

SillyCone a écrit
Cool ! C'est quoi l'unité du dessus ? Hygro/thermostat style STC-1000 ?
SHT2000 thermostat/hygrostat, la meme chose il me semble?
Dernière modification par Plotchiplocth (06 mai 2019 à 22:05)
Hors ligne

Plotchiplocth a écrit
SillyCone a écrit
Cool ! C'est quoi l'unité du dessus ? Hygro/thermostat style STC-1000 ?
SHT2000 thermostat/hygrostat, la meme chose il me semble?
Non, c'est le même boîtier mais le STC1000 ne fait que thermostat.
Du coup le SHT2000 il a 4 relais ? (2 pour l'hygro et 2 pour le thermo ?)
Hors ligne